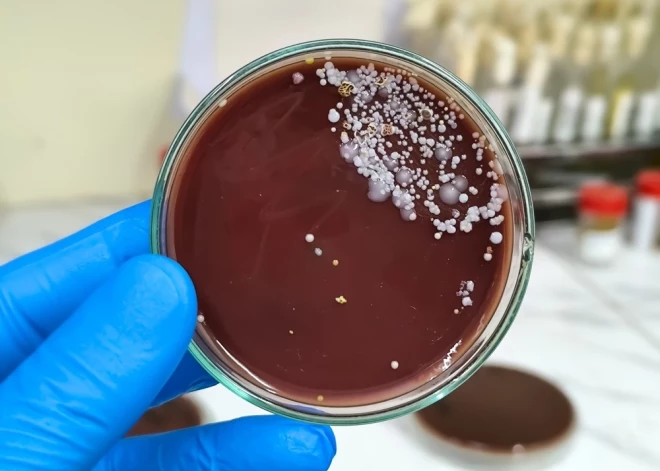

Пациенты в больницах по всей Европе в опасности: распространяется серьезная инфекция

Устойчивый к лекарствам грибок "стремительно" распространяется в больницах Европы, и органы здравоохранения призывают принять дополнительные меры для борьбы с ним.
Как сообщает Euronews, этот грибок, Candidozyma auris или C. auris, легко распространяется в медицинских учреждениях. Инфекции могут быть серьезными, особенно для уже заболевших пациентов, говорится в новом докладе Европейского центра профилактики и контроля заболеваний (ECDC).
По данным ECDC, в период с 2013 по 2023 год в Европейском союзе и близлежащих странах было зарегистрировано более 4 000 случаев заболевания, причем с течением времени число случаев значительно увеличивалось.
Больше всего случаев заболевания зафиксировано в Испании, Греции, Италии, Румынии и Германии, а Кипр, Франция и Германия сообщили о недавних вспышках. В 2023 году грибок, который ранее был известен как Candida auris, был обнаружен в 18 странах.
В некоторых частях Европы C. auris сейчас "настолько распространен, что уже невозможно выделить вспышки, он почти эндемичен в больницах", - сказал на пресс-брифинге Диамантис Плачурас, руководитель группы ECDC по антимикробной резистентности и инфекциям, связанным с оказанием медицинской помощи.
Однако истинное число жертв, скорее всего, занижено. Среди 36 европейских стран, включенных в новый отчет, только в 17 есть национальные программы наблюдения за C. auris, и только в 15 - специальные рекомендации по профилактике и контролю инфекций.
Способность грибка выживать на поверхностях и медицинском оборудовании, а также быстро распространяться между пациентами делает борьбу с ним сложной задачей, считают в ECDC. Не все обычные дезинфицирующие средства для больниц действуют против него, поэтому регулярной уборки недостаточно для предотвращения его распространения.
Хотя у инфицированных людей может подняться температура и появиться озноб, C. auris не имеет общего набора симптомов. Они могут варьироваться в зависимости от того, где произошло заражение - в кровотоке, в ране или в ушах.
"Это очень тревожно и, безусловно, представляет угрозу для безопасности пациентов в больницах по всей Европе", - сказал Плачурас.
Ранее Otkrito.lv сообщал о тои, что в Европе разбушевалась опасная заразная болезнь - ее переносят комары.








